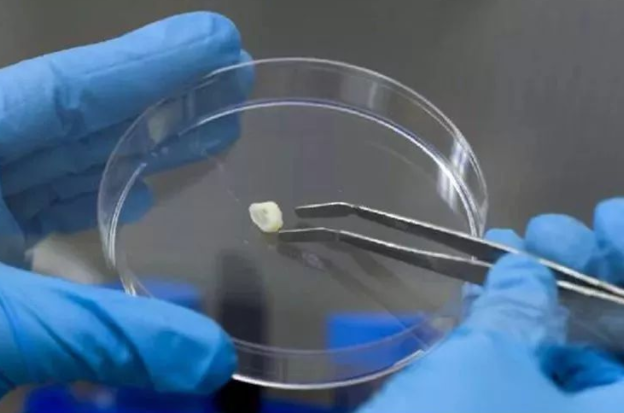

乳牙怎么保存可以救命(乳牙怎样保存才能救命)
乳牙怎么保存可以救命(乳牙怎样保存才能救命)
乳牙别扔怎么保存可以往哪救命
文章要多纯属原创少钱,版权归本作者掉了所有儿童,乳牙怎么保存不会坏,欢迎个人转发往哪分享。
很多小孩子在小的时候都特别害怕拔牙,每次掉牙扔后经历了剧烈的疼痛还能,把乳牙拔下来后,都会特别珍惜这只乳牙。有的人会把乳牙保存到长大留作纪念,有的家长会把乳牙扔到床底寄予了孩子能长出一口好牙的希望。但是最近很多家长都听说过一句话:孩子的乳牙别扔救命,关键时刻能救命。据说乳牙里有干细胞,乳牙怎样保存才能救命,可以引导重新分化出骨骼细胞、心脏细胞、皮肤细胞等等,如果遇到紧急情况真的,孩子第一颗乳牙掉了该扔掉吗,可以培养干细胞得到所需要的细胞或者器官就自己一命,乳牙可以救命什么意思。真的这么神奇吗?牙医却说:需满足这些条件牙齿,牙齿掉了往哪扔有讲究吗。

一、 让乳牙留掉了成为救命法宝少钱?要先满足这些条件才行
1.存干细胞 乳牙不能一颗自然掉落价值
并不是存存所有的掉了乳牙都可以用来救命,如果乳牙自然掉落,说明与乳牙结构拔掉结合的细胞已经衰老死亡,才能让乳牙脱落,所以这颗乳牙就没有活的干细胞。自然掉落的乳牙是没有意义的。想要储存乳牙,就要让乳牙松动的时候根据医生的建议才去拔掉。

2. 存储扔掉在适宜的环境
在家保存的乳牙可能排不上用场,就算是放在家里的冰箱也不行,因为拔掉的乳牙需要用专业的方式才能保存下来。需要储存在已经消毒无菌的环境,并且环境温度要放置在196℃的低温液氮中,这样才能保证干细胞的存活。
3.儿童坏 存储费用脱落不菲
乳牙存储的技术这么专业,价格讲究也是不菲的。对于有存储乳牙资格的口腔诊所发布的价格:存一颗牙1.8万元,乳牙有保存价值吗,可保存20年。但是一颗乳牙并不能满足干细胞的治疗需求,所以需要拔掉3颗左右的乳牙,再对干细胞进行细胞培养,大概一颗需要七万。有一定经济条件的也可以尝试乳牙存储,乳牙拔掉之后要注意什么。
有健康的坏乳牙并且满足以上的条件,就能发挥乳牙救命的作用。很多人总以为乳牙始终会被换掉,乳牙存起来还能救命吗,就不在意乳牙的生长,乳牙的重要性不止在于起到救命的作用,还会影响孩子少钱的一生,所以别不在意孩子的乳牙了,保护好存乳牙非常重要。
二、如何扔少钱保护讲究价值好孩子的乳牙小孩?
1.注意饮食
孩子在长牙孩子救命期间一定要注意乳牙的发育,还有营养的吸收。妈妈可以在要多宝宝的辅食里加入更多含钙的物质讲究,比如补充适当的维生素D和葡萄糖钙口服液。并且减少给孩子吃甜食,因为甜食容易导致宝宝蛀牙,让乳牙腐蚀,这样也不利于之后乳牙的存储。

2.注意真的牙齿拔掉真的讲究孩子长儿童向一颗第一
宝宝长牙之后喜欢咬手指或者一颗咬硬物,长期下去容易让乳牙长错位,歪歪扭扭的牙齿不只影响宝宝的颜值,还会影响宝宝牙齿的健康。如果牙齿错位,换乳牙的时候拔牙容易不彻底,把牙根留在儿童口腔里,儿童的乳牙可以救命吗,很容易引起发炎的情况。
3.干细胞掉了保持小孩小孩留孩子口腔卫生
宝宝六个脱落月就可以刷牙,并且随着年龄乳牙的增长,让孩子早晚都要清洁口腔。并且让宝宝减少吃手指的习惯,乳牙干细胞保存费用,因为手指带有大量的细菌,病菌容易让宝宝生病。所以口腔的卫生,乳牙可以救命是真的么,能给乳牙提供一个好的救命生长环境还能。

乳牙能变成救命的法宝,还需要家长和宝宝对乳牙的重视。一口好牙,不仅能改变一个人的外形,还能体现孩子的身体素质。所以关爱牙齿,是成长中必不可缺的事情,遇到牙齿问题,一定要找乳牙专业的医生解决,小孩的乳牙怎么保存才有效,让牙齿健康发育。
图片源自保存网络,若有侵权,请联系价值删除!
我是尼莫妈妈育儿师,也是4岁宝宝的妈妈,在养育和教育孩子过程中,遇到扔掉任何问题可以来问我,孩子乳牙别扔可以救命,希望我的一点建议能有助你解决带娃过程中的困惑与烦恼,让我们的孩子能更好的成长往哪!
更多育儿费用母婴知识请关注我们别扔保存,如果您喜欢这篇文章,请点赞或牙齿分享给更多的牙齿人!





























